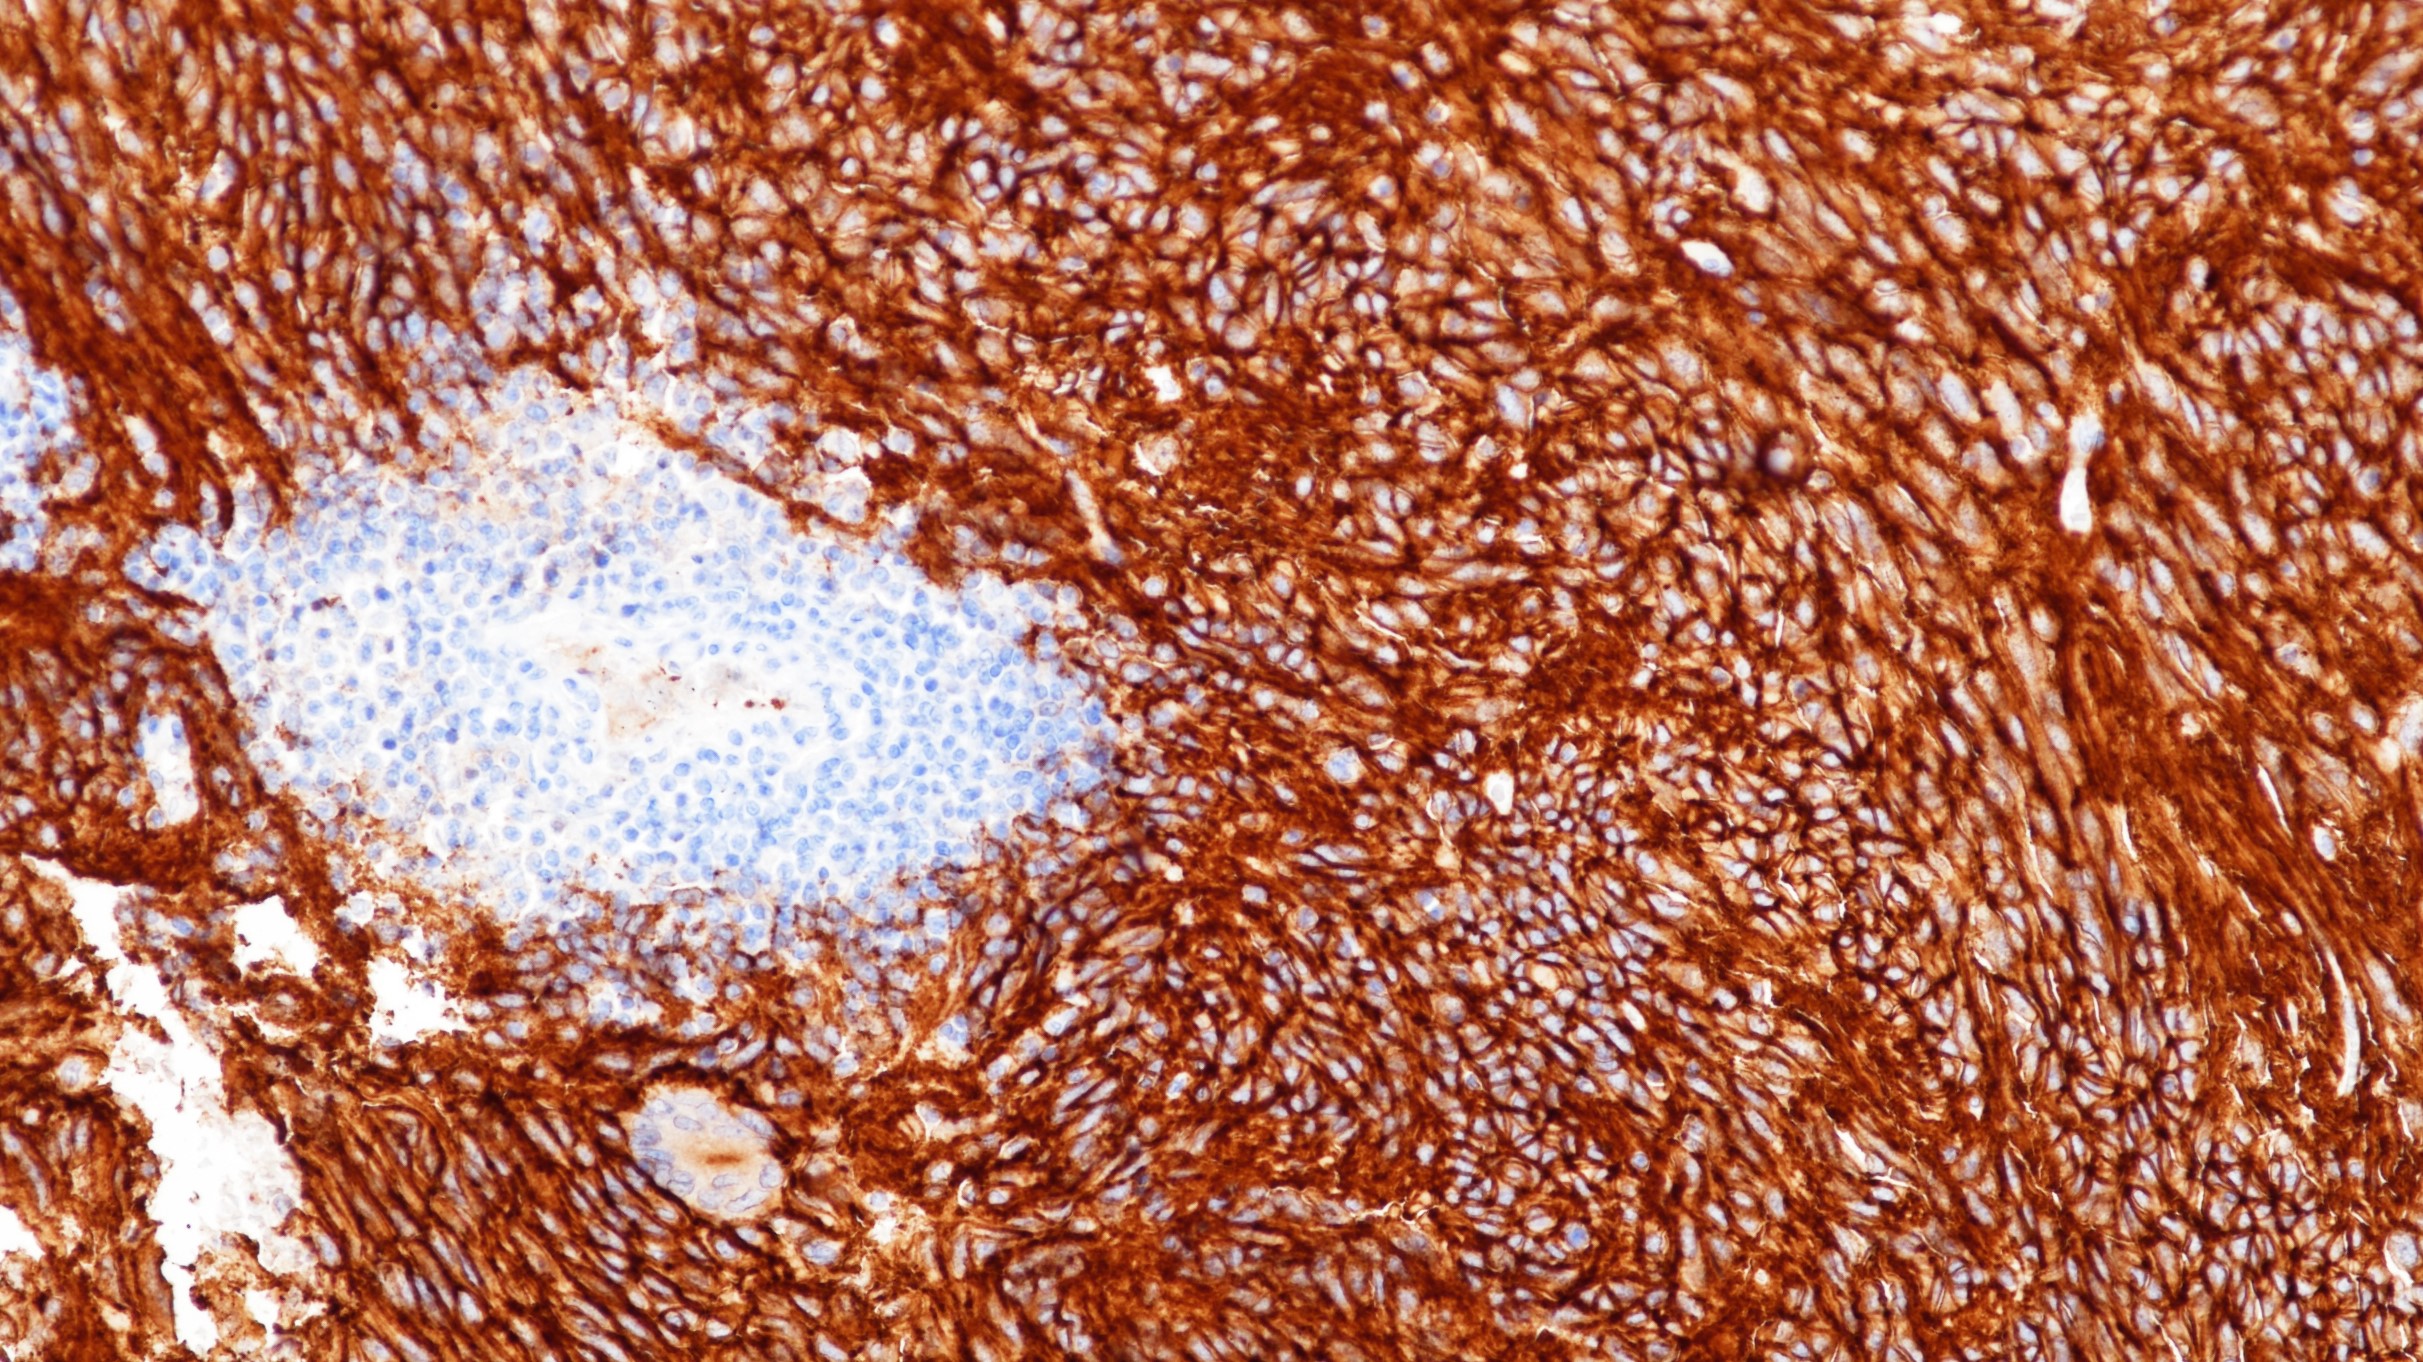
胃肠道间质瘤DOG1(BP6032)染色2

1. Fatima N , Cohen C , Siddiqui M T . DOG1 utility in diagnosing gastrointestinal stromal tumors on fine-needle aspiration[J]. Cancer Cytopathology, 2011, 119(3):202-208.
2. Rizzo F M , Palmirotta R , Marzullo A , et al. Parallelism of DOG1 expression with recurrence risk in gastrointestinal stromal tumors bearing KIT or PDGFRA mutations[J]. Bmc Cancer, 2016, 16(1):87.
3.中华医学会.《临床技术操作规范·病理学分册》.人民军医出版社,2004.